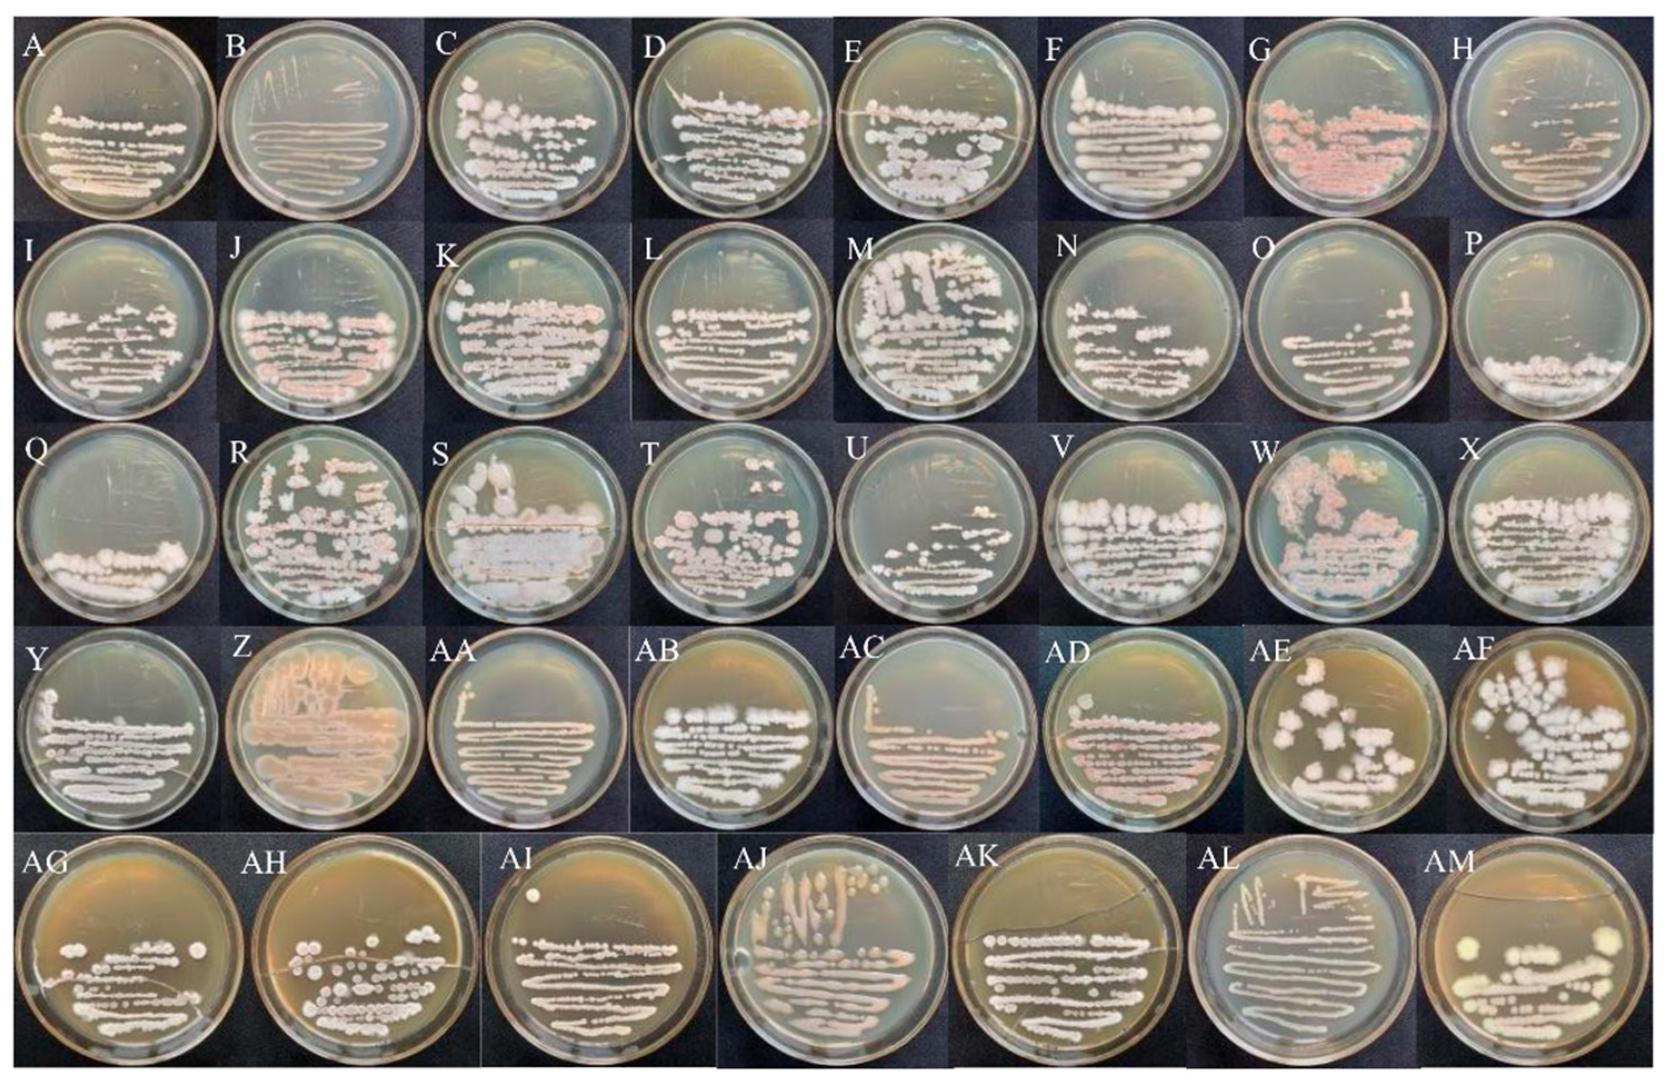
Horticulturae 08 00991 g001

Characterization and Antagonistic Effect of Culturable Apple-Phyllosphere Endophytic Bacteria from the Cold Plateau in Yunnan, China
Abstract
Highlights
- The endophytic community in apple leaves relates to geographic locations, apple varieties, and environment, providing the basis to explain the mechanisms underlying the establishment of apple endophytic communities and may help to devise apple disease management strategies.
- The dominant culturable endophytic bacteria Bacillus velezensis and B. subtilis successfully inhibit not only apple pathogens Alternaria alternata, Botryosphaeria dothidea, Valsa mali, Fusarium oxysporum, F. solani, and Rosellinia necatrix, but also F. oxysporum f. sp. cubense (banana Fusarium wilt) and Phytophthora nicotianae (tobacco black shank).
Abstract
1. Introduction
2. Materials and Methods
2.1. Sample Collection
2.2. Pathogen Strains
2.3. Isolation of Endophytic Bacteria from Apple Leaves
2.4. Morphological Characterization of Endophytic Bacteria
2.5. Molecular Identification of Endophytic Bacteria
2.6. Antagonistic Potential of Endophytic Bacteria
2.7. In Vitro Assay for Traits Related to Plant-Growth Promotion of the Endophytic Bacteria
2.7.1. Phosphate Solubilization
2.7.2. Potassium Solubilization
2.7.3. Nitrogen Fixation
2.8. Data Processing and Analysis
3. Results
3.1. Morphological Characteristics of Endophytic Bacteria
3.2. Molecular Characterization of Endophytic Bacteria
3.3. Diversity of Apple CEB in Yunnan Province
3.3.1. Geographical Distribution of CEB
3.3.2. Diversity of Endophytic Bacteria in Different Varieties
3.4. Antagonistic Effect of Endophytic Bacteria on Plant Pathogens
3.4.1. Antagonistic Effect on Apple Pathogens
3.4.2. Antagonistic Effect on Pathogens of Other Plants
3.5. Biological Functions of Endophytic Bacteria from Apple Leaves
4. Discussion
5. Conclusions
Supplementary Materials
Author Contributions
Funding
Data Availability Statement
Acknowledgments
Conflicts of Interest
References
- Zhou, J.T.; Zhao, D.Y.; Chen, Y.H.; Kang, G.D.; Chen, C.G. Analysis of apple producing area changes in China. J. Fruit Sci. 2021, 38, 372–384. [Google Scholar] [CrossRef]
- Li, K.M.; Hu, Z.R.; Chen, W.; Ma, J.; Wang, L.R.; Chen, Y. Apple producing areas and variety composition in Yunnan Province. China Fruit 2011, 2, 66–67. [Google Scholar] [CrossRef]
- Hu, Q.Y.; Hu, T.L.; Wang, Y.N.; Wang, S.T.; Cao, K.Q. Survey on the occurrence and distribution of apple diseases in China. Plant Prot. 2016, 42, 175–179. [Google Scholar] [CrossRef]
- Wang, S.T.; Wang, Y.N.; Cao, K.Q. Occurrence of and research progress in important apple diseases in China recent years. Plant Prot. 2018, 44, 13–25. [Google Scholar] [CrossRef]
- Jiao, B.F.; Sun, B.B. Development and enlightenment on the agriculture for sustaining and environmental preseruation in Japan. China Popul. Resour. Environ. 2009, 19, 70–76. [Google Scholar] [CrossRef]
- Pu, S.G. Study on pesticide use behavior and control of apple farmers. Agric. Technol. Equip. 2020, 367, 141–142. [Google Scholar] [CrossRef]
- Muresan, L.E. Culturable Bacterial and Fungal Endophytes from Apple Tissues and Their Potential for Biological Control of Venturia Inaequalis; The University of Guelph: Guelph, ON, Canada, 2017. [Google Scholar]
- Tamošiune, I.; Staniene, G.; Haimi, P.; Stanys, V.; Rugienius, R.; Baniulis, D. Endophytic Bacillus and Pseudomonas spp. modulate apple shoot growth, cellular redox balance, and protein expression under in vitro conditions. Front. Recent Dev. Plant Sci. 2018, 9, 889. [Google Scholar] [CrossRef]
- White, J.F.; Chang, X.; Kingsley, K.L.; Zhang, Q.; Chiaranunt, P.; Micci, A.; Velazquez, F.; Elmore, M.; Crane, S.; Li, S.; et al. Endophytic bacteria in grass crop growth promotion and biostimulation. Grass Res. 2021, 1, 5. [Google Scholar] [CrossRef]
- Zhang, Q.L.; Yang, Y.H.; Tan, Z.J.; Xie, B.Y. The progress of researches on endophytic functions in vegetations. Biotechnol. Bull. 2010, 7, 28–34. [Google Scholar] [CrossRef]
- Deng, Z.S.; Ma, Y.R.; He, Y.; Li, C.; Wang, F.; He, X.L.; Zhao, R.H. Screening endophytic bacteria strains of anti-apple tree decay (Valsa ceratosperma) from apple trees and their control effect. J. Microbiol. 2016, 36, 16–21. [Google Scholar] [CrossRef]
- Liu, J.; Ridgway, H.J.; Jones, E.E. Apple endophyte community is shaped by tissue type, cultivar and site and has members with biocontrol potential against Neonectria ditissima. J. Appl. Microbiol. 2020, 128, 1735–1753. [Google Scholar] [CrossRef]
- Miliute, I.; Buzaite, O.; Gelvonauskiene, D.; Sasnauskas, A.; Stanys, V.; Baniulis, D. Plant growth promoting and antagonistic properties of endophytic bacteria isolated from domestic apple. Zemdirb.-Agric. 2016, 103, 77–82. [Google Scholar] [CrossRef]
- Padder, S.A.; Mansoor, S.; Bhat, S.A.; Baba, T.R.; Rather, R.A.; Wani, S.M.; Popescu, S.M.; Sofi, S.; Aziz, M.A.; Hefft, D.I.; et al. Bacterial Endophyte Community Dynamics in Apple (Malus domestica Borkh.) Germplasm and Their Evaluation for Scab Management Strategies. J. Fungi 2021, 7, 923. [Google Scholar] [CrossRef]
- Yang, Y. Research on the Development of Apple Industry in China, 1st ed.; China Agricultural Science and Technology Press: Beijing, China, 2013. [Google Scholar]
- Carper, D.L.; Carrell, A.A.; Kueppers, L.M.; Frank, A.C. Bacterial endophyte communities in Pinus flexilis are structured by host age, tissue type, and environmental factors. Plant Soil 2018, 428, 335–352. [Google Scholar] [CrossRef]
- Dai, P.B.; Zhang, R.; Sun, G.Y. A checklist of pathogenic fungi on apple in China. Res. Pap. 2021, 40, 936–964. [Google Scholar] [CrossRef]
- Cun, H.C. Effect of Two Fungicides on Controlling Maize Gray Leaf Spot and Yield and Diversity Analysis of Endophytes in Maize Seedling Roots; Yunnan Agricultural University: Kunming, Yunnan, 2019. [Google Scholar]
- Liu, L.F.; Cun, H.C.; He, P.F.; Di, Y.N.; Wu, Y.X.; He, L.L.; Li, F.S.; He, Y.Q. Isolation, identification and multiple function analyses of sugarcane endophytes. Chin. J. Trop. Crops 2019, 40, 1144–1152. [Google Scholar] [CrossRef]
- Dong, X.Z.; Cai, M.Y. Manual of Identification of Common Bacterial Systems, 1st ed.; Science Press: Beijing, China, 2001. [Google Scholar]
- He, P.F. Genomic Analysis of B9601-Y2 Strain and Partial Functions Confirmation; Huazhong Agricultural University: Wuhan, China, 2014. [Google Scholar]
- He, J.; Zhang, L.L.; Zhao, L.Y.; Kang, Z.S.; Hang, L.L.; Yan, X. Identification of the endophytic strain longA from apple twig and its antifungal mechanism against Valsa mali. Microbiol. China 2016, 43, 2254–2260. [Google Scholar] [CrossRef]
- Yin, B.Z.; Liu, B.Y.; Liu, P.; Zhang, Y.C. Control effect of endophytic bacteria in Apple bark on apple tree decay (Valsa ceratosperma). Jiangsu Agric. Sci. 2017, 45, 84–86. [Google Scholar] [CrossRef]
- YaÑez-Ocampo, G.; Mora-Herrera, M.E.; Wong-Villarreal, A.; Denisse, M.; De La PortillaL-López, N.; Lugo, J.; Vaca-PaulÍn, R.; Águila, P.D. Isolated phosphate-solubilizing soil bacteria promotes in vitro growth of Solanum tuberosum L. Pol. J. Microbiol. 2020, 69, 357–365. [Google Scholar] [CrossRef]
- Li, N.; Wang, S.S.; Ma, L.L.; Liu, Y.H.; Xiu, Y.B.; Li, X.H.; Xiang, G.D.; Hu, D.N.; Guo, X.M.; Zhang, W.Y. Phosphate-solubilizing capacity of two bacteria strains and it’s effect on maize growth and the phosphorus fractions in red soil. J. Plant Nutr. Fertil. 2021, 27, 275–283. [Google Scholar] [CrossRef]
- Liu, X.; Kong, F.Y.; Zhang, C.S.; Wang, J.; Feng, C.; Zhao, J. Isolation and identification of the potassium-releasing bacteria from tobacco rhizosphere. Chin. Tob. Sci. 2012, 33, 28–31. [Google Scholar] [CrossRef]
- Xu, X.F. Study on the exopolysaccharides produced by Paenibacillus bovis sp. nov BD3526 in nitrogen-free solid culture medium. Sci. Technol. Food Ind. 2017, 38, 95–99. [Google Scholar] [CrossRef]
- Sever, Z.; Ivić, D.; Kos, T.; Miličević, T. Identification of Fusarium species isolated from stored apple fruit in Croatia. Arhiv. Za. Higijenu. Rada. i. toksikologiju. 2012, 63, 463–469. [Google Scholar] [CrossRef] [PubMed]
- Madhu, G.S.; Nabi, S.U.; Mir, J.I.; Raja, W.H.; Sheikh, M.A.; Sharma, O.C.; Singh, D.B. Alternaria leaf and fruit spot in apple: Symptoms, cause and management. Eur. J. Biotechnol. Biosci. 2020, 8, 24–26. [Google Scholar]
- Granado, J.; Thürig, B.; Kieffer, E.; Petrini, L.; Flieβbach, A.; Tamm, L.; Weibel, F.P.; Wyss, G.S. Culturable fungi of stored ’Golden Delicious’ apple fruits: A one-season comparison study of organic and integrated production systems in Switzerland. Microb. Ecol. 2008, 56, 720–732. [Google Scholar] [CrossRef]
- Afandhi, A.; Choliq, F.A.; Anggrilika, W.S.H.; Tarno, H. Distribution of the endophytic fungi in apple leaves. J. Agric. Sci. 2018, 40, 91–100. [Google Scholar] [CrossRef]
- Hirakue, A.; Sugiyama, S. Relationship between foliar endophytes and apple cultivar disease resistance in an organic orchard. Biol. Control 2018, 127, 139–144. [Google Scholar] [CrossRef]
- Martin, P.L.; Peter, K. Quantification of Colletotrichum fioriniae in orchards and deciduous forests indicates it is primarily a leaf endophyte. Phytopathology 2020, 111, 333–344. [Google Scholar] [CrossRef]
- Popp, C.; Grunewaldt-Stöcker, G.; Maiss, E. A soil-free method for assessing pathogenicity of fungal isolates from apple roots. J. Plant Dis. Prot. 2019, 126, 329–341. [Google Scholar] [CrossRef]
- Wang, Y.H.; Li, Y.L.; Chang, L.; Yu, H.R.; Zhou, Z.; Qu, L.J. Isolation and identification of endophytic fungi resistant to three apple pathogens from the branches of Malus sieversii. J. Fruit Sci. 2020, 37, 390–396. [Google Scholar] [CrossRef]
- Chiellini, C.; Lombardo, K.; Mocali, S.; Miceli, E.; Fani, R. Pseudomonas strains isolated from different environmental niches exhibit different antagonistic ability. Monit Zool Ital. 2019, 31, 399–420. [Google Scholar] [CrossRef]
- Larkin, B.G.; Hunt, L.S.; Ramsey, P.W. Foliar nutrients shape fungal endophyte communities in Western white pine (Pinus monticola) with implications for white-tailed deer herbivory. Fungal Ecol. 2012, 5, 252–260. [Google Scholar] [CrossRef]
- Alekseev, V.Y.; Veselova, S.V.; Sarvarova, E.R.; IV Maksimov, I.V. Growth-promoting activity of endophytic bacteria of the genus Bacillus. In Proceedings of the 2nd International Scientific Conference “Plants and Microbes: The Future of Biotechnology”, Saratov, Russia, 5–9 October 2020. [Google Scholar] [CrossRef]
- Li, Y.L.; Wang, Y.H.; Chang, L.; Yu, H.R.; Zhou, Z.; Zhao, W.X.; Qu, L.J. Isolation and identification of endophytic bacteria from Xinjiang wild apple (Malus sieversii) and their antagonism against three pathogens of apple trees. Sci. Silvae Sin. 2020, 56, 97–104. [Google Scholar] [CrossRef]
- Olivieri, L.; Saville, R.J.; Gange, A.C.; Xu, X.M. Apple endophyte community in relation to location, scion and rootstock genotypes and susceptibility to European canker. FEMS Microbiol Ecol. 2021, 97, fiab131. [Google Scholar] [CrossRef]
- Liu, J.; Abdelfattah, A.; Norelli, J.; Burchard, E.; Schena, L.; Droby, S.; Wisniewski, M. Apple endophytic microbiota of different rootstock/scion combinations suggests a genotype-specific influence. Microbiome 2018, 6, 18. [Google Scholar] [CrossRef]
- Wang, L.; Li, J.; Yang, F.; Raza, W.; Huang, Q.; Shen, Q. Application of bioorganic fertilizer significantly increased apple yields and shaped bacterial community structure in orchard soil. Microb. Ecol. 2017, 73, 404–416. [Google Scholar] [CrossRef]
- Saunders, M.; Glenn, A.E.; Kohn, L.M. Exploring the evolutionary ecology of fungal endophytes in agricultural systems: Using functional traits to reveal mechanisms in community processes. Evol. Appl. 2010, 3, 525–537. [Google Scholar] [CrossRef]
- Li, H.Y.; Wei, D.Q.; Shen, M.; Zhou, Z.O. Endophytes and their role in phytoremediation. Fungal Divers. 2012, 54, 11–18. [Google Scholar] [CrossRef]
- Gómez-Lama Cabanás, C.; Schilirò, E.; Valverde-Corredor, A.; Mercado-Blanco, J. The biocontrol endophytic bacterium Pseudomonas fluorescens PICF7 induces systemic defense responses in aerial tissues upon colonization of olive roots. Front. Microbiol. 2014, 5, 427. [Google Scholar] [CrossRef]

| Ecological Type of Production Area | Region | B. subtilis | B. velezensis | B. licheniformis | B. safensis | B. pumilus | Priestia megaterium |
|---|---|---|---|---|---|---|---|
| Northeast main apple-production area in Yunnan | Zhaotong | 4/6 | 3/6 | 4/6 | 2/6 | 1/6 | 0 |
| Rocky desertification apple-production area in Yunnan | Honghe, Luxi, and Kunming Stone Forest | 15/21 | 18/21 | 12/21 | 9/21 | 6/21 | 3/21 |
| Northwest mornity apple production area in Yunnan | Lijiang, Ninglang | 6/6 | 6/6 | 6/6 | 1/6 | 2/6 | 0 |
| Early- and medium-ripening in Yunnan | Qujing, Malong | 5/7 | 6/7 | 5/7 | 6/7 | 3/7 | 0 |
| Central Kunming apple-production area in Yunnan | Kunming, Tuanjie Township | 5/5 | 5/5 | 4/5 | 2/5 | 1/5 | 0 |
| Varieties | B. subtilis | B. velezensis | B. licheniformis | B. safensis | B. pumilus | Priestia megaterium |
|---|---|---|---|---|---|---|
| Red Fuji | 3/4 | 3/4 | 4/4 | 2/4 | 3/4 | 1/4 |
| Red General | 3/3 | 3/3 | 3/3 | 3/3 | 1/3 | 0 |
| Gala | 2/3 | 2/3 | 1/3 | 0 | 0 | 0 |
| Golden Handsome | 3/3 | 2/3 | 3/3 | 1/3 | 1/3 | 0 |
| Endophyte | Alternaria alternata | Botryosphaeria dothidea | Valsa mali | Fusarium oxysporum | Fusarium solani | Rosellinia necatrix | ||||||
|---|---|---|---|---|---|---|---|---|---|---|---|---|
| Species | IB/cm | IR/% | IB/cm | IR/% | IB/cm | IR/% | IB/cm | IR/% | IB/cm | IR/% | IB/cm | IR/% |
| B. subtilis | 0.48 ± 0.0160 a | 35.85 ± 0.38 a | 0.26 ± 0.0153 a | 34.10 ± 0.37 a | 0.60 ± 0.0478 a | 40.04 ± 0.53 a | 0.37 ± 0.0265 a | 34.00 ± 0.74 a | 0.39 ± 0.0322 a | 34.87 ± 0.42 a | 0.39 ± 0.0494 a | 37.83 ± 0.69 a |
| B. velezensis | 0.55 ± 0.0170 a | 32.03 ± 0.56 a | 0.32 ± 0.0252 a | 33.58 ± 0.62 a | 0.59 ± 0.0571 a | 40.88 ± 0.65 a | 0.42 ± 0.0308 a | 34.07 ± 0.50 a | 0.31 ± 0.0303 ab | 32.91 ± 0.41 a | 0.34 ± 0.0533 a | 38.49 ± 0.59 a |
| B. licheniformis | 0.25 ± 0.0486 b | 24.40 ± 3.95 b | 0.06 ± 0.0205 bc | 18.42 ± 4.14 b | 0.11 ± 0.0340 b | 24.50 ± 5.04 c | 0.03 ± 0.0188 b | 18.96 ± 4.25 b | 0.17 ± 0.0478 abc | 19.20 ± 4.31 b | 0.12 ± 0.0292 a | 29.12 ± 3.79 b |
| B. safensis | 0.10 ± 0.0447 bc | 15.34 ± 6.86 c | 0.17 ± 0.0644 ab | 11.45 ± 4.19 c | 0.38 ± 0.0559 ab | 28.98 ± 2.29 bc | 0.00 ± 0.0000 b | 0.00 ± 0.00 c | 0.00 ± 0.0000 c | 0.00 ± 0.00 c | 0.09 ± 0.0404 a | 25.29 ± 3.08 b |
| B. pumilus | 0.26 ± 0.1017 b | 23.15 ± 6.79 b | 0.26 ± 0.0563 a | 31.46 ± 1.42 a | 0.59 ± 0.1353 a | 35.55 ± 2.96 ab | 0.20 ± 0.0906 ab | 21.88 ± 6.43 b | 0.11 ± 0.0581 bc | 21.59 ± 6.44 b | 0.31 ± 0.1503 a | 23.05 ± 8.17 b |
| Priestia megaterium | 0.00 ± 0.0000 d | 0.00 ± 0.00 d | 0.00 ± 0.0000 c | 0.00 ± 0.00 d | 0.00 ± 0.0000 b | 0.00 ± 0.00 d | 0.00 ± 0.0000 b | 0.00 ± 0.00 c | 0.00 ± 0.0000 c | 0.00 ± 0.00 c | 0.00 ± 0.0000 a | 0.00 ± 0.00 c |
| Endophyte | Alternaria alternata | Fusarium oxysporum | Rhizoctonia solani | Botrytis cinerea | Phytophthora nicotianae | ||||||
|---|---|---|---|---|---|---|---|---|---|---|---|
| Species | Strain | IB/cm | IR/% | IB/cm | IR/% | IB/cm | IR/% | IB/cm | IR/% | IB/cm | IR/% |
| B. velezensis | b9 | 0.30 ± 0.0258 ab | 37.54 ± 3.92 a | 0.23 ± 0.0882 abc | 23.96 ± 0.52 ab | 0.17 ± 0.0333 c | 10.98 ± 0.38 d | 0.23 ± 0.0882 a | 28.83 ± 1.19 ab | 0.30 ± 0.0408 b | 33.11 ± 3.24 a |
| b12 | 0.35 ± 0.0342 a | 33.37 ± 5.74 a | 0.33 ± 0.0500 ab | 26.29 ± 1.06 a | 0.30 ± 0.0577 abc | 15.15 ± 0.76 b | 0.10 ± 0.0000 a | 25.67 ± 2.81 bc | 0.17 ± 0.0882 bc | 23.90 ± 0.63 ab | |
| b30 | 0.33 ± 0.0211 a | 36.83 ± 5.10 a | 0.40 ± 0.0471 a | 26.68 ± 0.43 a | 0.17 ± 0.0333 c | 11.36 ± 0.66 cd | 0.20 ± 0.0577 a | 23.09 ± 1.09 cd | 0.20 ± 0.0000 bc | 28.30 ± 0.00 a | |
| b34 | 0.20 ± 0.0000 bc | 28.33 ± 1.67 a | 0.15 ± 0.0289 bc | 26.17 ± 1.33 a | 0.33 ± 0.0667 ab | 14.39 ± 1.65 bc | 0.10 ± 0.0000 a | 19.40 ± 0.47 de | 0.00 ± 0.0000 c | 12.93 ± 0.81 b | |
| b43 | 0.32 ± 0.0543 a | 32.14 ± 2.46 a | 0.13 ± 0.0333 bc | 19.79 ± 0.52 b | 0.27 ± 0.0333 bc | 11.74 ± 1.00 cd | 0.10 ± 0.0000 a | 18.85 ± 0.80 e | 0.38 ± 0.0364 ab | 34.82 ± 4.48 a | |
| B. safensis | b8 | 0.10 ± 0.0000 c | 24.29 ± 1.43 a | 0.21 ± 0.0423 abc | 5.83 ± 1.18 c | 0.43 ± 0.0333 a | 14.02 ± 1.00 bc | 0.20 ± 0.0577 a | 24.51 ± 0.50 c | 0.53 ± 0.1054 a | 27.38 ± 1.79 a |
| B. subtilis | b33 | 0.10 ± 0.0000 c | 31.67 ± 0.96 a | 0.10 ± 0.0000 c | 22.66 ± 3.91 ab | 0.17 ± 0.0333 c | 20.07 ± 0.38 a | 0.17 ± 0.0333 a | 31.53 ± 0.45 a | 0.00 ± 0.0000 c | 13.04 ± 1.23 b |
| Species | Strain | Nitrogen Fixation | Inorganic Phosphorus Solubilization | Potassium Solubilization | Organic Phosphorus Solubilization |
|---|---|---|---|---|---|
| B. subtilis | b3 | +++ | + | - | ++ |
| b4 | +++ | ++ | ++ | ++ | |
| b5 | ++ | +++ | ++ | + | |
| b10 | ++ | +++ | - | ++ | |
| b11 | ++ | +++ | - | + | |
| b13 | + | + | - | ++ | |
| b16 | +++ | + | + | + | |
| b17 | +++ | - | + | +++ | |
| b18 | ++ | ++ | - | +++ | |
| b20 | +++ | ++ | + | +++ | |
| b21 | + | ++ | - | ++ | |
| b23 | +++ | +++ | - | ++ | |
| b26 | + | ++ | ++ | +++ | |
| b32 | + | + | - | ++ | |
| b33 | + | + | - | ++ | |
| b36 | ++ | + | - | + | |
| b37 | + | + | - | + | |
| b40 | ++ | + | - | - | |
| B. velezensis | b1 | ++ | + | - | + |
| b9 | ++ | - | - | +++ | |
| b12 | ++ | + | - | +++ | |
| b14 | ++ | + | - | +++ | |
| b15 | + | - | - | + | |
| b22 | - | - | - | - | |
| b27 | ++ | ++ | - | + | |
| b30 | + | ++ | + | +++ | |
| b34 | ++ | - | - | +++ | |
| b38 | +++ | ++ | - | + | |
| b43 | + | + | - | +++ | |
| B. licheniformis | b7 | +++ | +++ | ++ | + |
| b24 | +++ | - | - | + | |
| b28 | +++ | +++ | ++ | + | |
| b39 | ++ | ++ | - | - | |
| b42 | ++ | + | - | - | |
| B. safensis | b2 | - | - | - | - |
| b8 | - | +++ | - | ++ | |
| B. pumilus | b29 | - | + | - | - |
| b31 | ++ | - | - | + | |
| Priestia megaterium | b6 | + | +++ | + | +++ |
Publisher’s Note: MDPI stays neutral with regard to jurisdictional claims in published maps and institutional affiliations. |
© 2022 by the authors. Licensee MDPI, Basel, Switzerland. This article is an open access article distributed under the terms and conditions of the Creative Commons Attribution (CC BY) license (https://creativecommons.org/licenses/by/4.0/).
Share and Cite
Pan, X.; He, P.; Zhou, C.; Cun, H.; He, P.; Munir, S.; Wu, Y.; Ahmed, A.; Asad, S.; Ma, J.; et al. Characterization and Antagonistic Effect of Culturable Apple-Phyllosphere Endophytic Bacteria from the Cold Plateau in Yunnan, China. Horticulturae 2022, 8, 991. https://doi.org/10.3390/horticulturae8110991
Pan X, He P, Zhou C, Cun H, He P, Munir S, Wu Y, Ahmed A, Asad S, Ma J, et al. Characterization and Antagonistic Effect of Culturable Apple-Phyllosphere Endophytic Bacteria from the Cold Plateau in Yunnan, China. Horticulturae. 2022; 8(11):991. https://doi.org/10.3390/horticulturae8110991
Chicago/Turabian StylePan, Xinlong, Pengbo He, Cong Zhou, Haichun Cun, Pengfei He, Shahzad Munir, Yixin Wu, Ayesha Ahmed, Suhail Asad, Jun Ma, and et al. 2022. "Characterization and Antagonistic Effect of Culturable Apple-Phyllosphere Endophytic Bacteria from the Cold Plateau in Yunnan, China" Horticulturae 8, no. 11: 991. https://doi.org/10.3390/horticulturae8110991
APA StylePan, X., He, P., Zhou, C., Cun, H., He, P., Munir, S., Wu, Y., Ahmed, A., Asad, S., Ma, J., Ma, Y., Zhang, Y., Cao, K., Kong, B., & He, Y. (2022). Characterization and Antagonistic Effect of Culturable Apple-Phyllosphere Endophytic Bacteria from the Cold Plateau in Yunnan, China. Horticulturae, 8(11), 991. https://doi.org/10.3390/horticulturae8110991

